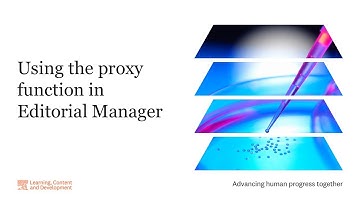
Using the proxy function in Editorial Manager

⬇ DOWNLOAD NOW
Kalau muncul iklan pop-up, tutup lalu klik tombol kembali
Download lagu Elsevier: Using the Declaration Tool in Editorial Manager secara gratis hanya untuk keperluan promosi. Dukung artis favorit kamu dengan membeli musik original di iTunes atau platform resmi lainnya.
 Elsevier: Author submission process overview
Elsevier: Author submission process overview
 Elsevier: Submission status explainer
Elsevier: Submission status explainer
 How to use the CRediT (contributor roles taxonomy) system in Editorial Manager
How to use the CRediT (contributor roles taxonomy) system in Editorial Manager
 Elsevier: Checking the status of your submission in Editorial Manager
Elsevier: Checking the status of your submission in Editorial Manager
Using the proxy function in Editorial Manager
Using the proxy function in Editorial Manager
 Reporting in Editorial Manager: Reviewer Performance Report
Reporting in Editorial Manager: Reviewer Performance Report
 Preparing to submit your manuscript in Editorial Manager
Preparing to submit your manuscript in Editorial Manager
 Submitting a review in Editorial Manager
Submitting a review in Editorial Manager